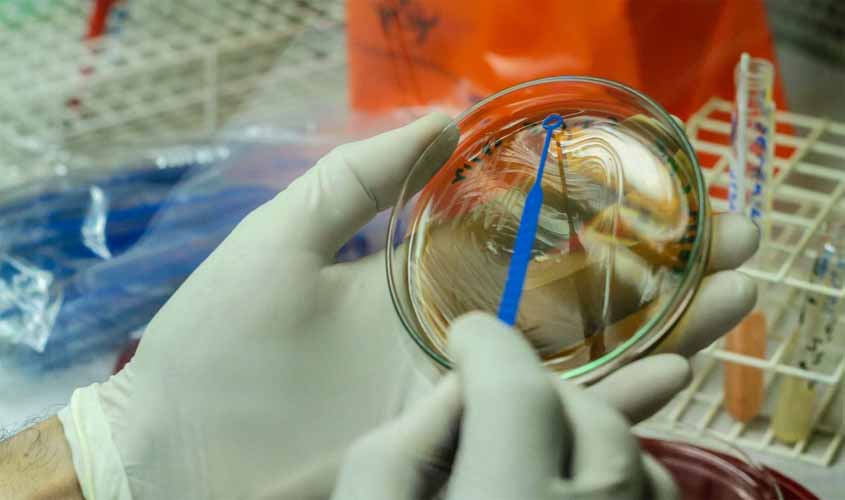
Casos suspeitos de Monkeypox em Rondônia são descartados; resultado é emitido por laboratório referência

Bolsonaro tem culpa por provável assassinato de indigenista e jornalista
É urgente acabar com esse governo, com a destruição das florestas e as mortes dos que defendem a vida
Queria não dizer isso sobre o presidente da república, mas sou jornalista em Rondônia, porção da Amazônia que sofre com os impactos dos discursos e políticas antiambientais desse governo maldito.
Da campanha a posse de Bolsonaro, testemunhei o crescimento dos ataques às florestas, aos povos que vivem nelas, à jornalistas e ativistas ambientais.
Vi aumentar dia a dia o perigo a jornalistas e ativistas que Bolsonaro acusou de agirem contra os interesses do país.
No mês em que Jair Bolsonaro tomou posse como presidente decidi empenhar meus esforços, sozinha e sem recursos, à cobertura do desmantelo ambiental no estado.
Fui a vários territórios indígenas, quilombolas e reservas extrativistas para mostrar como e por que, estavam sendo invadidos com mais velocidade e violência.
Ninguém me contou. Eu vi e divulguei ameaças e crimes contra os povos originários e ao meio ambiente.
Também chamaram de aventura o meu trabalho, como Bolsonaro fez ao saber do desaparecimento do indigenista Bruno Pereira e do jornalista britânico Dom Phillips, na Terra Indígena do Vale do Javari, no Amazonas.
Também sofri ameaças. Nas redes sociais e pessoalmente.
Sigo desafiando narrativas oficiais e cada vez com mais dificuldade e medo.
Por isso posso dizer que Bolsonaro tem responsabilidade sim, com os assassinatos de Bruno e Dom. E que terá também por outros que ocorram em razão de denúncias de crimes ambientais, pois são estimulados com ações e omissões do governo.
Com o enfraquecimento dos órgãos de fiscalização e a parceria criminosa de governos com legislativos, invasores de áreas protegidas agem confiantes na impunidade.
Não à toa, Bolsonaro lidera as pesquisas de intenção de votos no meu estado.
Quem invade, destrói a mata, mata e quer mais.
A capital, Porto Velho, aparece hoje em terceiro lugar no ranking de municípios com mais emissões de gases do efeito estufa, resultado do desmatamento acelerado.
Qualquer jornalista e ativista que se oponha ou denuncie conflitos entre quem destrói e quem protege, corre o risco de ser assassinado.
Há dois anos mataram Ari Uru Eu Wau Wau, guardião da floresta. Ele fazia parte de um grupo que monitorava invasões nas aldeias de seu povo. Quem matou e quem mandou matar, não se sabe.
Hoje Bruno e Dom Phillips.
Amanhã, por que não eu? Por que não a Neidinha Surui, uma das protagonistas do premiado filme The Territory, que expôs ao mundo o mal que Bolsonaro faz à Amazônia e a seus povos?
Floresta em pé nenhuma vida a menos!
É urgente acabar com esse governo, com a destruição das florestas e as mortes dos que defendem a vida.
Eleger Bolsonaro presidente foi uma aventura desgraçada.
Casos suspeitos de Monkeypox em Rondônia são descartados; resultado é emitido por laboratório referência
Agevisa recebeu o resultado não reagente das amostras encaminhadas para o Funed/MG dos casos suspeitos de Monkeypox
Judiciário de RO realiza palestra sobre Qualidade de Vida no Trabalho com servidores, magistrados e estagiários
Trabalhadores terceirizados e de outros órgãos à disposição do TJRO também participam da pesquisa
Notebooks são entregues em Ouro Preto em ação que envolveu o Fórum da comarca
A entrega foi feita pelo juiz João Valério, idealizador do Pedal Solidário de Natal

Comentários
Deveriam voltar a exigir diploma para ser jornalista. O chorume jornalístico está cada vez pior. Militância pura, eivada de acefalia e sempre dando um prognóstico de culpabilidade do oponente mental. Veículos de desinformação aparelhados para direcionar o povo ao abismo da mentira.
que coisa feia falar mal do nosso Presidente, nossa autoridade com palavras pejorativas, agora tudo que acontece é ele o culpado, se tem uma pessoa que defende nossa amazônia é ele, porque os demais presidente nunca defendeu como ele, a midia sempre querendo derrubá-lo, mas não vão conseguir, melhor PRESIDENTE que o Brasil teve até hj, cuidado com as palavras de ofensas.
Os BOLSONARISTAS da direita e da extrema-direita não querem admitir, mas são só eles que assassinam as lideranças que estão no caminho deles. Foi assim com Chico Mendes, foi assim com Mariele Franco e foi assim também com estes dois cidadãos. BOLSONARO e seus "cupinchas" envergonham o BRASIL perante o mundo civilizado. Então, alguém acreditaria que foi o Lula, o PT ou os seus seguidores quem mandou eliminar esses dois cidadãos? BOLSONARO não gosta de lideranças nem morre de amores por quem pensa diferente dele e de seus seguidores. O atraso na compra das vacinas matou quantos brasileiros? Milhares. E que diferença faz morrerem "somente" duas pessoas agora? É a História que mostra quem são os bárbaros, os assassinos frios, os maus brasileiros. PARABÉNS, LUCIANA OLIVEIRA! E cuide-se: essa gente vive sempre com as mãos sujas de sangue. São assassinos e psicopatas a serviço do atraso e da falta de civilização.
Fico aqui pensando, como tem uns comentários chulos e com falta de prepara, será que os comentaristas aqui, sabem pelo menos o que miliciano, fascista. Só por não aceitar que perderam um eleição, aonde o nosso Brasil somente cresceu após os grandes atos de corrupção e roubalheira dos governos anteriores, E ainda vejo um jornal eletrônico totalmente Parcial em suas matérias. Temos que lutar mais para mudar esta mentalidade tão medíocre.
sebastian baia, QUEM MATOU O MAR MORTO FOI O BOSTANARO, isto é, BOSTANARO ESTÁ MATANDO A AMAZONIA; 33 MILHÕES PASSANDO FOME NO PAÍS QUE MAIS PRODUZ ALIMENTOS; 650 MIL BRASILEIROS MORTOS PELA COVID; BOSTANARO QUER A GUERRA CIVEL PARA MATAR MAIS BRASILEIROS......
O que mais chama a atenção é a comparação dos comentários feitos por pessoas educadas, instruídas, bem informadas com os dos que representam a barbárie, a violência, o atraso. Pensem nisso ao votarem.
Kardec, Jesus sentenciou: "Amai-vos uns aos outros"; bostanaro distribuindo armas aos milicianos relincha: 'ARMAI-VOS UNS AOS OUTROS"; bostanaro quer uma guerra civel,
As pesquisas eleitorais mostram que o Brasil ainda tem cerca de 30% de analfabetos... Um ser humano que ainda se manifestar a favor do Miliciano Mor e Verdugo do Planalto, é muita ignorância!!! Ou é analfabetismo, ou bandidagem. Querer que um monstro imbecil e carniceiro prossiga mais 4 anos derramando sangue do povo e sujando o nome de nosso país mundo afora, é muuuuita jumentice. Sigam zurrando, jumentos bolsonaristas.
O BRASIL ESTÁ DOENTE! Uma simples matéria jornalistica é capaz de despertar tanto ódio. A Bíblia diz no Evangelho de Mateus Capitulo 22. Respondeu Jesus: " ‘Ame o Senhor, o seu Deus de todo o seu coração, de toda a sua alma e de todo o seu entendimento’. Este é o primeiro e maior mandamento. E o segundo é semelhante a ele: ‘Ame o seu próximo como a si mesmo’. DESTACO: ‘Ame o seu próximo como a si mesmo’. O AMOR É A MAIOR ORAÇÃO. VAMOS AMAR E UNIR O BRASIL.
Parabéns pela matéria corajosa e corretíssima!!! O que me faz rir é a raiva com que latem os bosomínions daqui. Um mais ignorante que o outro. O tal do Osvaldo Dias resume o nível de instrução dessa tropa. Escreveu "mal gosto" ... Quando até as crianças de 7 anos já sabem que o correto é MAU GOSTO... Mas é isso! Quem se alimenta em cochos, degustando ração e complementando a alimentação na pastagem, só tem mesmo chifres na cabeça...
(des)governo do bostanaro: 650 mil brasileiros mortos pela covid, simplesmente porque o bostanaro disse que era apenas uma gripezinha; porque para matar os brasileiros demorou a comprar as vacinas; 33 milhões de brasileiros passando fome (nunca antes visto neste país); inflação nos dois dígitos; juros nas alturas; desmatamento colossal; garimpos ilegais; bostanaro fala em "deus" mas libera armas para armar sabe "deus" quem; bostanaro semeia ventos, vai colher tempestades; bostanaro entregou o brasil ao centrão;
Engraçado, os caras sabiam do perigo e mesmo assim foram, sem nenhuma escolta, agora querem culpar alguém pela irresponsabilidade dos dois, eles tinham ciência do perigo que corriam, agora culpar o presidente ai é muita pilantragem deste jornalista de meia tigela.
Que mediocridade de reportagem, muito de mal gosto a replicabilidade deste tipo de reportagem.
Petista, você sabia que nos desgovernos Lula e Dilma, aumentou em 168% as morte de Indígenas no Brasil, agora que posar de salvadora da pátria, vai pra lá lacradora de merda.
é so o que faltava. ta com falta de materia é???
VAI CAÇAR O QUE FAZER SUA DESOCUPADA, COM CERTEZA VOCÊS DA MÍDIA PODRE, QUEREM AQUELE LADRÃO DE VOLTA, PRA ACABAR DE SAQUEAR O PAÍS. INFELIZMENTE QUERIDA, TENHO UMA COISA PRA TE FALAR, VÃO TER QUE ENGOLIR MAIS 04 ANOS,KKKKKKK. OU ENTÃO VOCÊS DA MÍDIA PODRE VÃO PRA CUBA, VENEZUELA ETC.....IDIOTAAAAAAAAA.
Tem uma moça la na rua de casa que ela engravidou. Acredito que o fato dela estar grávida é culpa do Bolsonaro, que não mandou entregar uma camisinha para ela.
Jornalista Vagabundo. Esquerda Filha da Puta mesmo. Notícia Vagabunda.
Envie Comentários utilizando sua conta do Facebook